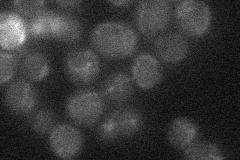
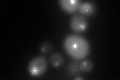

View description
Alpha-tubulin; associates with beta-tubulin (Tub2p) to form tubulin dimer, which polymerizes to form microtubules; expressed at lower level than Tub1p
Localization:
Intensity:
Fold change:
Significance:
-
C’ GFP library in SD

punctate:cytosol49.48 -
N' NOP1pr-GFP in SD

punctate253.134 -
N' TEF2pr-mCherry in SD

punctate220.94 -
N' NATIVEpr-GFP in SD
below threshold14.2891 -
N' TEF2pr-VC and Cyto-VN in SD

punctate50.9046 -
C’ GFP library in SD+DTT
punctate.cytosol66.671.34Yes -
C’ GFP library in SD+H2O2

punctate.cytosol53.081.07No -
C’ GFP library in Starvation Media

punctateN/AN/AYes -
C’ GFP library on the background of Pup2-DaMP

punctate:cytosol -
C’ GFP library on the background of CCT mutant

punctate:cytosol43.5140.879253No
